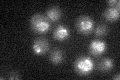
YMR129W

View description
Nuclear pore membrane glycoprotein; may be involved in duplication of nuclear pores and nuclear pore complexes during S-phase;
Localization:
Intensity:
Fold change:
Significance:
-
C’ GFP library in SD

nuclear periphery22.05 -
N' NOP1pr-GFP in SD

cell periphery,nuclear periphery61.4054 -
N' TEF2pr-mCherry in SD

ER,punctate96.4202 -
N' NATIVEpr-GFP in SD

below threshold19.6739 -
N' TEF2pr-VC and Cyto-VN in SD

punctate32.5131 -
C’ GFP library in SD+DTT

nuclear periphery21.290.96No -
C’ GFP library in SD+H2O2

nuclear periphery18.560.84No -
C’ GFP library in Starvation Media
nuclear periphery22.311.01No -
C’ GFP library on the background of Pup2-DaMP

nuclear periphery -
C’ GFP library on the background of CCT mutant

nuclear periphery18.05760.818638No
